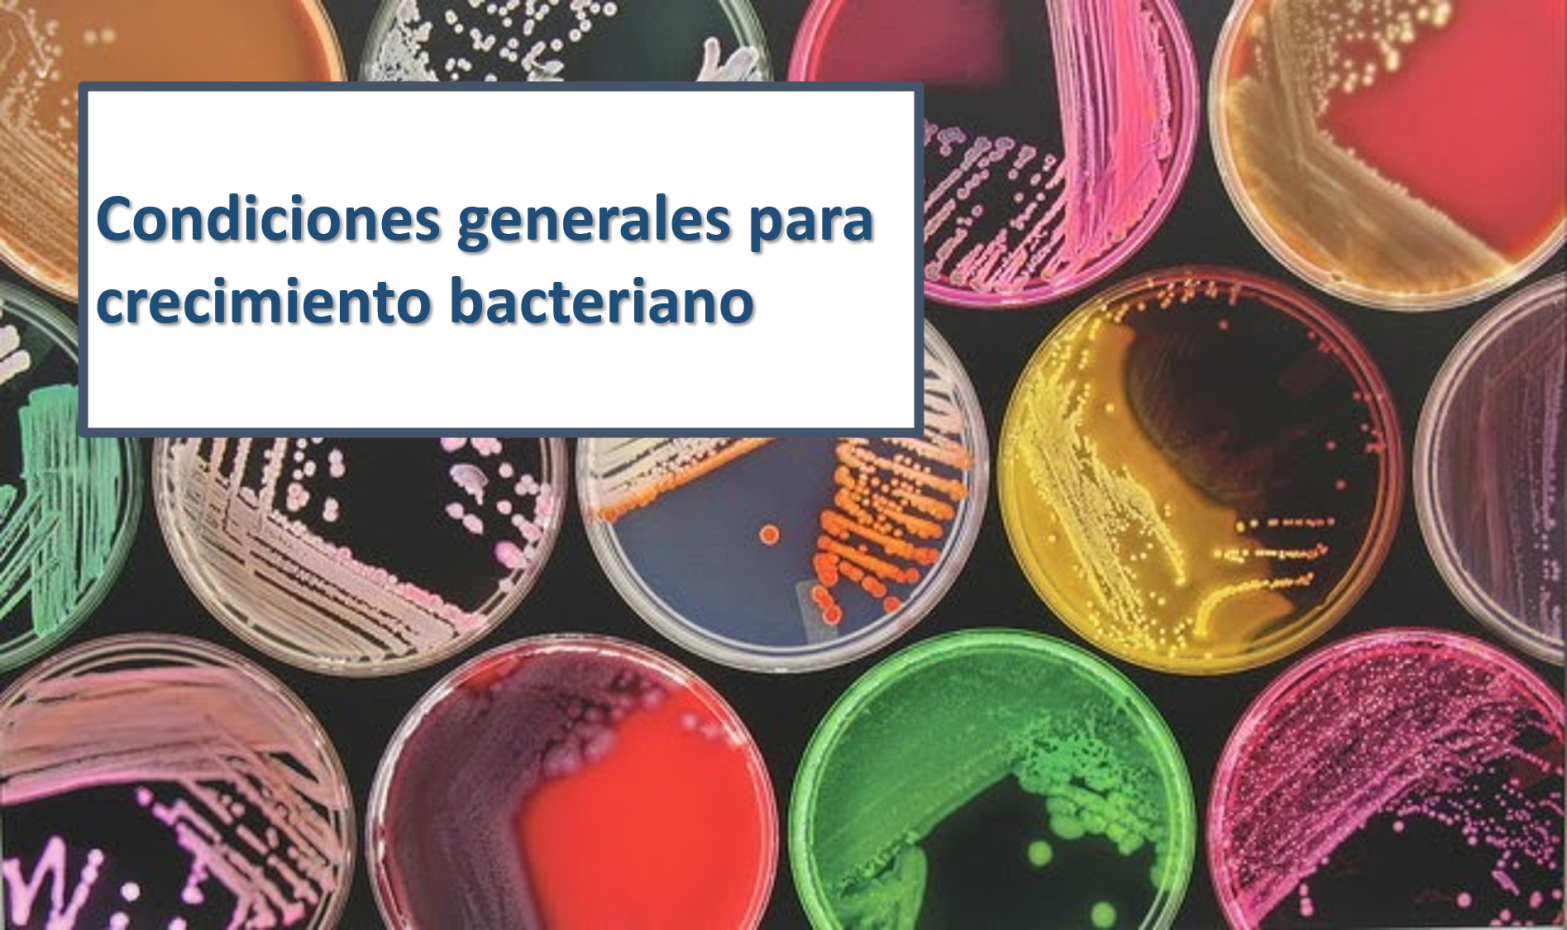
crecimiento bacteriano microbiologia

Las bacterias patógenas requieren diversos factores para desarrollarse y multiplicarse
Archivo de etiqueta: microorganismos
Las 10 enfermedades de transmisión alimentaria (ETA’s) más comunes
10 intoxicaciones transmitidas por alimentos más comunes
Las bacterias patógenas requieren diversos factores para desarrollarse y multiplicarse

10 intoxicaciones transmitidas por alimentos más comunes